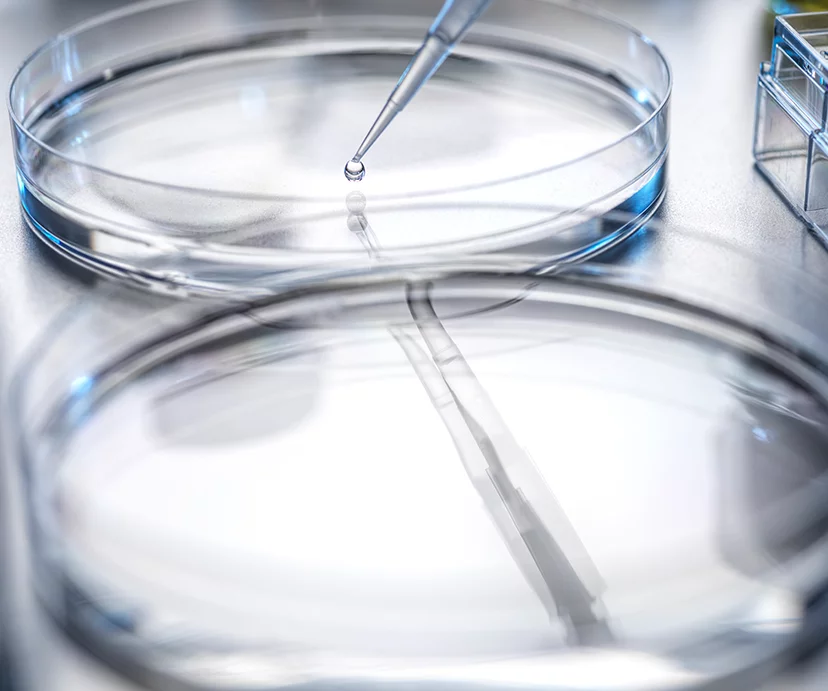

CẤY MỠ TẾ BÀO GỐC
Tỷ lệ sống cao và hiệu quả tái tạo vượt qua những hạn chế của phương pháp cấy mỡ truyền thống
Cấy mỡ tế bào gốc không chỉ đơn thuần giúp tăng thể tích cho các vùng bị lõm, mà còn mang lại tỷ lệ sống cao và hiệu quả tái tạo da, giúp tạo nên độ đầy đặn tự nhiên, hài hòa và duy trì lâu dài theo thời gian.
Hiệu ứng Homing
Homing Effect
Tế bào tự tìm đến các mô bị tổn thương,bám vào và thúc đẩy phục hồi tại những vùng cần thiết.
Hiệu ứng Paracrine
Paracrine Effect
Tế bào tiết ra các chất giúp kích thích các tế bào xung quanh phục hồi và tăng sinh collagen, từ đó cải thiện độ đàn hồi và săn chắc của vùng được điều trị
Phân hóa
Differentiation
Tế bào phân hóa thành các loại tế bào cần thiết, giúp khôi phục mô và tăng tỷ lệ sống của tế bào.
Tự tái tạo
Self-renewal
Các tế bào gốc tự phân chia, tạo ra các tế bào gốc mới, đồng thời duy trì sự tái tạo liên tục và ổn định số lượng tế bào.
Vì sao nên thực hiện cấy mỡ bằng tế bào gốc?
So với cấy mỡ thông thường, phương pháp cấy mỡ bằng tế bào gốc thế hệ 3 của AB có tỷ lệ sống mô mỡ cao hơn rõ rệt.
AB áp dụng tỷ lệ 1:9 giữa tế bào gốc và mỡ, giúp cải thiện đáng kể tỷ lệ sống của mỡ, đạt lên đến 80–90%.
*Vì sao quy trình làm sạch enzyme lại quan trọng?
Để thu được tế bào gốc (SVF) từ mỡ, cần sử dụng enzyme (collagenase) có tác dụng phân giải collagen và cấu trúc nền của mô mỡ, giúp tách các tế bào ra khỏi mô.
Tuy nhiên, nếu enzyme này còn tồn dư trong vật liệu được đưa vào cơ thể, có thể gây viêm hoặc kích hoạt phản ứng miễn dịch. Vì vậy, việc làm sạch và loại bỏ hoàn toàn enzyme thông qua quy trình rửa là vô cùng quan trọng.
Ưu điểm khác biệt của cấy mỡ tế bào gốc thế hệ 3
chiết xuất được 3 triệu tế bào
trung bình 98,5%
không còn dư lượng enzyme
trong vòng 2–30 phút,
không làm tổn thương tế bào
1. Tỷ lệ thu được tế bào cao giúp nâng cao tỷ lệ sống khi cấy mỡ
Nhờ thiết bị chiết xuất tiên tiến, cùng một lượng mỡ có thể thu được nhiều tế bào gốc hơn, giúp nâng cao tỷ lệ bám mỡ và kéo dài thời gian duy trì hiệu quả.

2. Tỷ lệ tế bào sống cao giúp duy trì hiệu quả cấy mỡ lâu dài
Nhờ ứng dụng quy trình chính xác, giảm thiểu tổn thương tế bào, phương pháp này đảm bảo tỷ lệ sống của tế bào cao hơn, đồng thời hỗ trợ duy trì độ căng đầy ổn định sau khi cấy mỡ.

3. Thủ thuật an toàn với mỡ tinh khiết cao, không lo biến chứng
Thông qua quy trình rửa lặp đi lặp lại hơn 3 lần, enzyme dư được loại bỏ hoàn toàn, chỉ sử dụng những tế bào mỡ sạch và tinh khiết cho quá trình cấy.

4. Cùng một lượng mỡ, số lượng tế bào sống nhiều hơn giúp nâng cao hiệu quả cấy mỡ.
Với công nghệ chiết xuất độc quyền, quá trình xử lý giảm tối đa tổn thương tế bào, nhờ đó thu được 1,5–2 lần tế bào sống nhiều hơn so với phương pháp tự động thế hệ 2, giúp tăng hiệu quả cấy mỡ đáng kể.

[Nguồn] Dongkoo Bio&Pharma

ƯU ĐIỂM ĐẶC BIỆT CỦA AB
CẤY MỠ TẾ BÀO GỐC, TẠI SAO CHỌN AB
1. Tế bào gốc tiên tiến được thực hiện tại AB, cơ sở y tế tái tạo hiện đại.
Chỉ các cơ sở y tế tiên tiến về tái tạo, được Bộ Y tế và Phúc lợi chỉ định, mới được thực hiện nghiên cứu sử dụng tế bào và mô có nguồn gốc từ con người.


- Xây dựng cơ sở hạ tầng chuyên dụng cho y học tái tạo và nghiên cứu
- Đội ngũ chuyên trách nâng cao công nghệ y học tái tạo tiên tiến
- Xây dụng hệ thống duy trì chất lượng tế bào gốc
2. Bệnh viện thẩm mỹ AB là bệnh viện được chứng nhận Bác sĩ chủ chốt trong thực hiện liệu trình tế bào gốc.
Bác sĩ phụ trách điều trị tế bào gốc tại Bệnh viện Thẩm mỹ AB được chọn là bác sĩ chính thực hiện liệu trình tế bào gốc nhờ sở hữu công nghệ tế bào gốc thế hệ thứ 3 tiên tiến nhất.

3. Bệnh viện thẩm mỹ AB thực hiện thủ thuật tế bào gốc được chứng nhận với hệ thống quản lý chất lượng xuất sắc.
Bệnh viện thẩm mỹ AB được CGP công nhận hệ thống quản lý chất lượng tế bào gốc, mang đến liệu trình an toàn và hiệu quả cao.

4. Bệnh viện thẩm mỹ AB được chứng nhận hệ thống y tế đạt chuẩn quốc tế
Bệnh viện thẩm mỹ AB được Hiệp hội Y tế Quốc tế Hàn Quốc công nhận về hệ thống quản lý bệnh nhân, trình độ chuyên môn của đội ngũ y bác sĩ và độ an toàn trong phẫu thuật, nhờ đó cung cấp dịch vụ y tế ở một tầm cao mới.

- Hệ thống quản lý bệnh nhân đạt chuẩn quốc tế
- Trình độ chuyên môn của đội ngũ y bác sĩ và độ an toàn trong phẫu thuật
- Tuân thủ nghiêm ngặt đạo đức y tế và quản lý chất lượng dịch vụ
5. Xử lý và thực hiện thủ thuật trong ngày
Xây dựng hệ thống one-stop cho phép thực hiện kiểm tra khả năng gây mê, lấy mẫu mô, tách và cô đặc tế bào trong cùng một ngày.

6. Thực hiện liệu trình tế bào gốc an toàn, giảm thiểu nguy cơ nhiễm khuẩn và ô nhiễm
Nhờ sử dụng bộ kit một lần đã được tiệt trùng, lắp đặt bộ lọc HEPA, thực hiện phòng dịch và tiến hành kiểm tra trước thủ thuật cùng đánh giá khả năng gây mê tại trung tâm xét nghiệm, nguy cơ nhiễm trùng và lây nhiễm được giảm thiểu tối đa, đảm bảo môi trường thực hiện liệu trình an toàn tuyệt đối.

7. Hệ thống kiểm tra trọn gói(one-stop) tại trung tâm tế bào gốc AB
Việc vận hành trung tâm kiểm tra sức khỏe riêng không chỉ giúp rút ngắn thời gian kiểm tra và thực hiện liệu trình, mà còn cho phép tiến hành xét nghiệm máu ngay lập tức khi xảy ra tình huống khẩn cấp, đảm bảo xử lý kịp thời.
Có thể kiểm tra, nhận kết quả trong ngày và thực hiện liệu trình một cách nhanh chóng
Nhờ có kỹ thuật viên xét nghiệm lâm sàng thường trực tại viện, các kiểm tra chuyên môn được thực hiện một cách kỹ lưỡng và chuyên nghiệp.
8. Tổ chức các hội nghị quốc tế liên quan đến nâng cơ định kỳ và chống lão hóa
Dựa trên vô số kinh nghiệm lâm sàng và nghiên cứu về chống lão hóa, AB tiên phong dẫn đầu trong lĩnh vực học thuật.

9. Hệ thống hợp tác điều trị giữa bệnh viện đại học và các cơ sở y tế cấp cao.
Thiết lập hệ thống hợp tác y tế với Bệnh viện Bundang thuộc Đại học Quốc gia Seoul và Bệnh viện Sacred Heart Dongtan thuộc Đại học Hallym.

1. Tế bào gốc tiên tiến được thực hiện tại AB, cơ sở y tế tái tạo hiện đại.
Chỉ các cơ sở y tế tiên tiến về tái tạo, được Bộ Y tế và Phúc lợi chỉ định, mới được thực hiện nghiên cứu sử dụng tế bào và mô có nguồn gốc từ con người.


- Xây dựng cơ sở hạ tầng chuyên dụng cho y học tái tạo và nghiên cứu
- Đội ngũ chuyên trách nâng cao công nghệ y học tái tạo tiên tiến
- Xây dụng hệ thống duy trì chất lượng tế bào gốc
3. Bệnh viện thẩm mỹ AB thực hiện thủ thuật tế bào gốc được chứng nhận với hệ thống quản lý chất lượng xuất sắc.
Bệnh viện thẩm mỹ AB được CGP công nhận hệ thống quản lý chất lượng tế bào gốc, mang đến liệu trình an toàn và hiệu quả cao.

5. Xử lý và thực hiện thủ thuật trong ngày
Xây dựng hệ thống one-stop cho phép thực hiện kiểm tra khả năng gây mê, lấy mẫu mô, tách và cô đặc tế bào trong cùng một ngày.

7. Hệ thống kiểm tra trọn gói(one-stop) tại trung tâm tế bào gốc AB
Việc vận hành trung tâm kiểm tra sức khỏe riêng không chỉ giúp rút ngắn thời gian kiểm tra và thực hiện liệu trình, mà còn cho phép tiến hành xét nghiệm máu ngay lập tức khi xảy ra tình huống khẩn cấp, đảm bảo xử lý kịp thời.
Có thể kiểm tra, nhận kết quả trong ngày và thực hiện liệu trình một cách nhanh chóng
Nhờ có kỹ thuật viên xét nghiệm lâm sàng thường trực tại viện, các kiểm tra chuyên môn được thực hiện một cách kỹ lưỡng và chuyên nghiệp.
9. Hệ thống hợp tác điều trị giữa bệnh viện đại học và các cơ sở y tế cấp cao.
Thiết lập hệ thống hợp tác y tế với Bệnh viện Bundang thuộc Đại học Quốc gia Seoul và Bệnh viện Sacred Heart Dongtan thuộc Đại học Hallym.

2. Bệnh viện thẩm mỹ AB là bệnh viện được chứng nhận Bác sĩ chủ chốt trong thực hiện liệu trình tế bào gốc.
Bác sĩ phụ trách điều trị tế bào gốc tại Bệnh viện Thẩm mỹ AB được chọn là bác sĩ chính thực hiện liệu trình tế bào gốc nhờ sở hữu công nghệ tế bào gốc thế hệ thứ 3 tiên tiến nhất.

4. Bệnh viện thẩm mỹ AB được chứng nhận hệ thống y tế đạt chuẩn quốc tế
Bệnh viện thẩm mỹ AB được Hiệp hội Y tế Quốc tế Hàn Quốc công nhận về hệ thống quản lý bệnh nhân, trình độ chuyên môn của đội ngũ y bác sĩ và độ an toàn trong phẫu thuật, nhờ đó cung cấp dịch vụ y tế ở một tầm cao mới.

- Hệ thống quản lý bệnh nhân đạt chuẩn quốc tế
- Trình độ chuyên môn của đội ngũ y bác sĩ và độ an toàn trong phẫu thuật
- Tuân thủ nghiêm ngặt đạo đức y tế và quản lý chất lượng dịch vụ
6. Thực hiện liệu trình tế bào gốc an toàn, giảm thiểu nguy cơ nhiễm khuẩn và ô nhiễm
Nhờ sử dụng bộ kit một lần đã được tiệt trùng, lắp đặt bộ lọc HEPA, thực hiện phòng dịch và tiến hành kiểm tra trước thủ thuật cùng đánh giá khả năng gây mê tại trung tâm xét nghiệm, nguy cơ nhiễm trùng và lây nhiễm được giảm thiểu tối đa, đảm bảo môi trường thực hiện liệu trình an toàn tuyệt đối.

8. Tổ chức các hội nghị quốc tế liên quan đến nâng cơ định kỳ và chống lão hóa
Dựa trên vô số kinh nghiệm lâm sàng và nghiên cứu về chống lão hóa, AB tiên phong dẫn đầu trong lĩnh vực học thuật.

Thông tin phẫu thuật cấy mỡ tế bào gốc
INFORMATION SURGERY
Thông tin phẫu thuật
Trước phẫu thuật
Khoảng 1 tiếng
Phương pháp gây mê
Gây mê cụ bộ / Gây mệ ngủ nhẹ
Đến viện điều trị
1 ~2 lần
Thời gian phục hồi
Sau 1~2 ngày
RECOMMEND SURGERY
Đối tượng gợi ý
Trường hợp có một số vùng cơ thể bị lõm sâu hoặc mất độ đàn hồi
Trường hợp gương mặt thiếu sức sống, mất thể tích, nhìn già hơn tuổi
Trường hợp muốn hiệu quả duy trì lâu dài hơn so với cấy mỡ thông thường
Trường hợp không muốn sử dụng vật liệu cấy ghép nhân tạo










